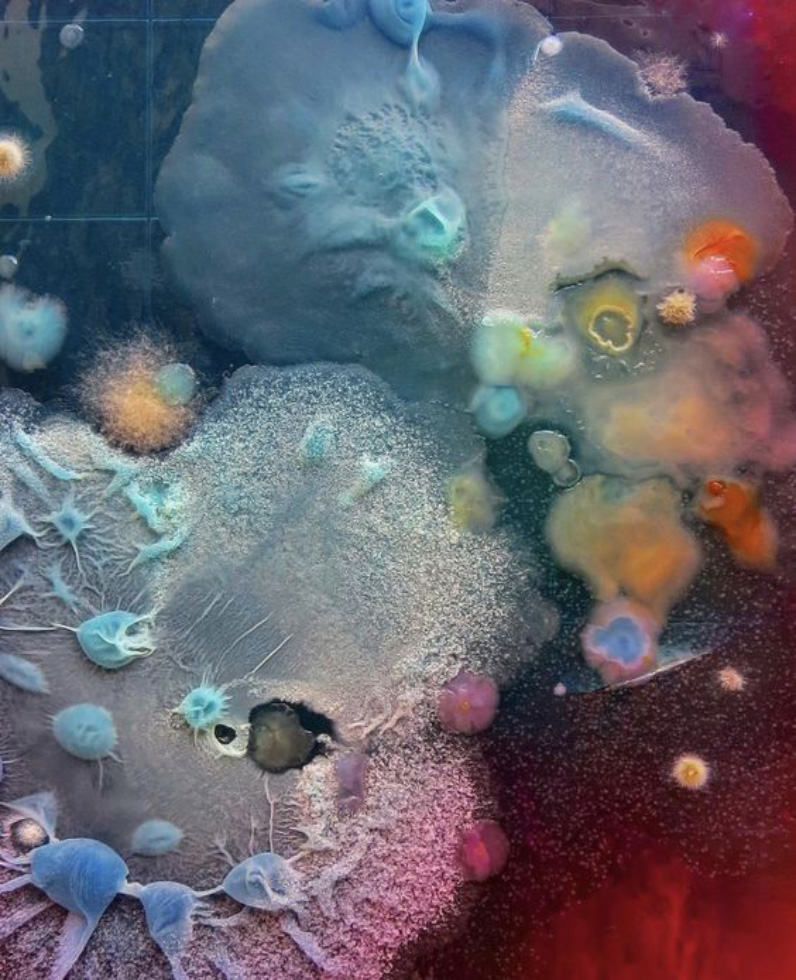

- Date
- 15 DECEMBER 2022
- Author
- AMÆMI
- Image by
- SISTER EFFECT
- Categories
- Music
Sister Effect: the meeting point between psychedelic sounds and their visual digital representations

Sister Effect is a DJ and light designer born in Athens and moved to Italy at the age of eighteen. Thanks to the discovery of electronic music, then she approaches Drum and bass until, years later, she gets to expand her musical interest more and more, specializing in the search for psychedelic, tribal, meditative sounds that can lead to an alternate state of consciousness. The artist's goal is to tell stories, both through the imaginary musical scenario and through the use of light design, recreating the visual representation of what she wants to convey with the sounds involved.

Tell us about yourself: who is Sister Effect, how is born and from what sonorities comes from.
I have always loved music since I remember myself. I grew up in Athens and moved to Italy, in Florence, by the end of 2006 when I was 18. I discovered electronic music and started exploring more deeply, going to parties, mainly raves, squats and underground clubs and visiting constantly the record store close to my home. I totally fell in love with drum and bass, got my first turntables and started buying records trying to mix them. It was quite hard at the beginning but never stopped exercising and after about one year, around 2009 I played at my first gig. I got soon involved in the local Dnb crew, playing at several parties. In 2011 I moved to Milan, started playing around Italy, mainly in squats and in 2015 I became part of Double Drop, the resident Dnb crew of the historical squat Leoncavallo. I have always loved many different music genres, but I had never experimented them as a dj. I was in a loop, playing at many events and using only vinyls, so I didn’t have actually material to try something different, until 2020, when I invested into two cdjs, in order to be able to start a new digital library, definitely more affordable. Once the pandemic started I had plenty of time, and no gigs going on, to start finally experimenting with any kind of music. At that time several changes where happening to my private life and I was really lucky to meet some people that actually became a second family to me, and there was a great exchange also with music. I started getting everyday more interested in researching psychedelic sounds, meant not as a genre but as any kind of music that transports you to a different level of consciousness, from ambient, to Krautrock, dub, blues, jazz, tribal meditative rhythms, cosmic sounds, etc. I finally got rid of the typical idea of a dj playing mainly one genre and started appreciating the freedom of having no limits. Still in that process.
What do you want to transmit with your music?
What I would like to express with my music is first of all sharing my research with others. There is so much beautiful music and 100 lives wouldn’t be enough to find all that music alone. Sharing my view is trying to make people listen to new music. Another important aspect I love doing with music, is trying to tell a story, from the beginning till the end, it has to be a moment where you forget everything and start exploring new paths, even if just with your imagination, in order to live a new experience.

How do you reconcile living in a digitally advanced and extremely urban and industrial metropolis like Milan with the sounds you propose, which are instead more ancestral, reminds to forest and natural sounds, magical scenarios and slower rhythms together?
In my research I try not to exclude anything. After years playing music that was mainly “about the future” and also around 160-180 bpms, I noticed that more ancestral sounds, tribal rhythms, ambient sounds etc. have a deeper connection with our inner soul. It is like a feeling of natural frequency that connects us to the world, something that it is already inside us. As for getting to lower bpms, I really love playing stuff at 80 bpms, which can be at the same time downtempo or as fast as 160 bpms. I also believe that lower rhythms have a deeper body expression, sounds are dilated and moves can interest your whole body. It is like having more time for good stretching. As for the environment that surrounds me, after the pandemic I prefer more intimate spaces, I don’t like much clubs, I definitely prefer parties or situations in nature. As said before I try not to exclude anything, so if for example I have to play in an industrial space, I will probably be inspired with a more digital/ future selection rather than natural tribal sounds. It is like providing an adeguate soundtrack for the situation, but still keeping your identity.

How do you think the digital world has influenced your music?
From a practical point of view the most direct influence is the one I mentioned above, changing support, from a physical copy like vinyl to a digital file. This has given me the opportunity to expand my library in a more affordable way, as having immediate accessibility. When I was ordering physical copies I had to wait about 2 weeks to have my copy, which has never been an actual problem, it is just an important difference. Plus, with digital supports you can extend your mixing techniques, by looping stuff and using it in a more creative and constructive way. An important aspect though that can be considered in some way negative, is that as it is easier and more affordable to have access to digital files, the risk is to make a selection that it is not that accurate...of course it is something you can avoid if you can control your temporary enthusiasm and think about it a couple of times.
You are also a light designer: is there any connection between visual scenery and sound imagery? And if so, what is this correlation for you?
Yes my main job is as a lighting designer. I never thought my actual job and my passion for music could at some point meet. When I started working on installations it naturally came to add sound. Being active in the music scene has given me the opportunity to meet incredible artists, exchange ideas and start collaborations. We start with a concept, then music is made following that concept and at the final step I just imagine how that specific sound would look like visually in a physical but at the same time digital and intangible environment.

How do you see your areas of artistic competence changing in the future: light design/visual installations and djing in light of new worlds and new realities such as the augmented ones like, for example, the Metaverse one?
I am not sure about how this could work for my activity, but it is something I have thought about. Last April I visited the NFT art fair at the Kraftwerk in Berlin, and this made me think a lot, but still haven’t got a solid opinion about it. What I noticed is that many contents didn’t have an actual artistic value (or maybe I couldn’t find it), they where just 20 seconds loops of changing colors, and this made me think that maybe it is too accessible and less selective. It is a good thing on one hand, but on the other it can get a bit confusing. Thinking about my activity, as creating immersive installations (or playing music for somebody) I believe that being physically present with all of your senses interested it is something that can’t be replaced easily. At the same time I also experienced the VR installation “To the moon” by Laurie Anderson and Hsin-Chien Huang and it was incredible. You could actually fly in the space, walk on the moon and feel incredibly during this journey. Virtual reality is really powerful, it still misses though some elements like smell and taste(I know there are many researches and prototypes), but I guess it is just a matter of time before technology covers also this aspect in order it can be diffused on a larger scale.
What I don’t like personally, is when VR substitutes real life, but I think it can be a powerful instrument in giving the possibility to experience something that in real life isn’t possible, like in a dream, or a videogame. I believe it can be also an effective and more direct knowledge tool, or even a way to work on psychological disorders. Like everything, it depends on how it is used, but I believe it has much potential.

A question I always like to ask: which kind of performance, representative of your art, would you imagine being able to stage in the Metaverse?
I would create the most trippy and impossible environment, where everything that makes you happy is possible.
1. Dotekayu Do The Point Of Feeling - Mestra.Vestlud
2. Sukothai - Javier Marimon
3. Moon Dirt - Xia Ye
4. Dawn Celebrazion - Brothers Of Helios
5. Dogo Godov - Driftmachine
6. Mnogoljetije - Bicikl (kӣr's Akakije rework)
7. Drums - Laurie Spiegel
8. Abyssal Lights - 9BEATS